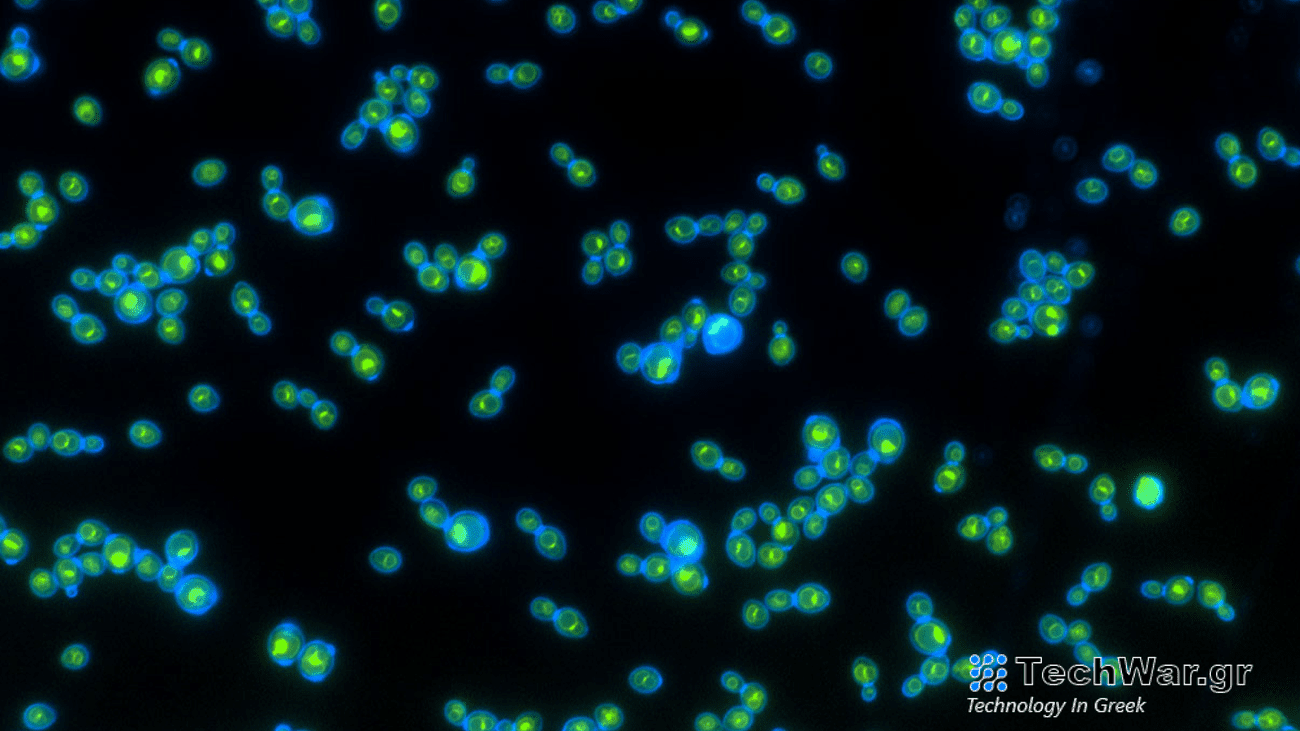
Green rhodopsin proteins inside the blue cell walls help these yeast grow faster when exposed to light.

Αυτή η μαγιά αγαπά το φως | Λαϊκή Επιστήμη
Σε αντίθεση με μερικά όμορφα μεταλλικά φυτά που ευδοκιμούν στο σκοτάδι, η μαγιά γενικά δεν λειτουργεί καλά στο φως. Αυτός ο μύκητας μετατρέπει τους υδατάνθρακες σε συστατικά για μπύρα ή ψωμί όταν αφήνεται να ζυμωθεί στο σκοτάδι. Πρέπει να φυλάσσεται σε σκοτεινά ξηρά μέρη, καθώς η έκθεση στο φως μπορεί να
εμπ
οδίσει τη ζύμωση να συμβεί μαζί. Ωστόσο,
μι
α ομάδα επιστημόνων έχει κατασκευάσει ένα στέλεχος ζύμης που μπορεί πραγματικά να λειτουργεί καλύτερα με το φως που θα μπορούσε να δώσει σε αυτούς τους μύκητες μια εξελικτική ώθηση με έναν απλό τρόπο. Τα ευρήματα περιγράφονται στο α
μελέτη που δημοσιεύτηκε στις 12 Ιανουαρίου στο περιοδικό
Τρέχουσα Βιολογία
.
[Related:
The key to tastier beer might be mutant yeast—with
notes
of banana
.]
«Ειλικρινά ήμασταν σοκαρισμένοι από το πόσο απλό ήταν να μετατρέψουμε τη μαγιά σε φωτότροφους (οργανισμούς που μπορούν να αξιοποιήσουν και να χρησιμοποιήσουν ενέργεια από το φως)» ο συν-συγγραφέας της μελέτης και κυτταρικός βιολόγος του Ινστιτούτου Τεχνολογίας της Τζόρτζια, Anthony Burnetti.
είπε σε δήλωση
. «Το μόνο που χρειαζόταν να κάνουμε ήταν να μετακινήσουμε ένα μόνο γονίδιο και αναπτύχθηκαν 2 τοις εκατό πιο γρήγορα στο φως παρά στο σκοτάδι. Χωρίς καμία λεπτομέρεια ή προσεκτική παραμόρφωση, απλά λειτούργησε.”
Δίνοντας στη ζύμη ένα τόσο εξελικτικά σημαντικό χαρακτηριστικό μπορεί να μας βοηθήσει να καταλάβουμε πώς προήλθε ο φωτοτροπισμός και πώς μπορεί να χρησιμοποιηθεί για τη μελέτη της εξέλιξης και της
παραγωγή
ς βιοκαυσίμων, καθώς και για το πώς γερνούν τα κύτταρα.
Δώσε του λίγη ενέργεια
Προηγούμενη εργασία σχετικά με την εξέλιξη της πολυκύτταρης ζωής από αυτήν την ερευνητική ομάδα ενέπνευσε τη νέα μελέτη. Σε
2023,
η ομάδα αποκάλυψε πώς θα μπορούσε ένας μονοκύτταρος πρότυπος οργανισμός που ονομάζεται μαγιά νιφάδας χιονιού
εξελίσσουν την πολυκυτταρικότητα πάνω από 3.000 γενιές
. Ωστόσο, ένας από τους σημαντικότερους περιορισμούς στα πειράματα εξέλιξής τους ήταν η έλλειψη ενέργειας.
«Το οξυγόνο δυσκολεύεται να διαχυθεί βαθιά στους ιστούς και ως αποτέλεσμα παίρνετε ιστούς χωρίς την ικανότητα να λαμβάνετε ενέργεια», είπε ο Burnetti. «Έψαχνα τρόπους να ξεπεράσω αυτόν τον ενεργειακό περιορισμό που βασίζεται στο οξυγόνο».
Το φως είναι ένας από τους τρόπους με τους οποίους οι οργανισμοί μπορούν να λάβουν ενεργειακή ώθηση χωρίς οξυγόνο. Ωστόσο, από εξελικτική άποψη, η ικανότητα ενός οργανισμού να μετατρέπει το φως σε χρησιμοποιήσιμη ενέργεια μπορεί να είναι περίπλοκη. Ο μοριακός μηχανισμός που επιτρέπει στα φυτά να χρησιμοποιούν το φως για ενέργεια απαιτεί πολυάριθμες πρωτεΐνες και γονίδια που είναι δύσκολο να συντεθούν και να μεταφερθούν σε άλλους οργανισμούς. Αυτό είναι δύσκολο στο εργαστήριο και μέσω φυσικών διεργασιών όπως η εξέλιξη.
Μια απλή ροδοψίνη
Τα φυτά δεν είναι οι μόνοι οργανισμοί που μπορούν να μετατρέψουν το φως σε ενέργεια. Μερικοί οργανισμοί στο φυτό μπορούν επίσης να χρησιμοποιήσουν αυτό το φως με τη βοήθεια του
ροδοψίνες
. Αυτές οι πρωτεΐνες μπορούν να μετατρέψουν το φως σε ενέργεια χωρίς επιπλέον κυτταρικό μηχανισμό.
«Οι ροδοψίνες βρίσκονται σε όλο το δέντρο της ζωής και προφανώς αποκτώνται από οργανισμούς που παίρνουν γονίδια ο ένας από τον άλλο κατά τη διάρκεια του εξελικτικού χρόνου», συν-συγγραφέας της μελέτης και Georgia
Tech
Ph.D. μαθητής Φθινόπωρο Πίτερσον
είπε σε δήλωση
.
[Related:
Scientists create a small, allegedly delicious piece of yeast-free pizza dough.
]
Μια γενετική ανταλλαγή όπως αυτή ονομάζεται α
οριζόντια μεταφορά γονιδίων
, όπου οι γενετικές πληροφορίες μοιράζονται μεταξύ οργανισμών που δεν σχετίζονται στενά. Μια οριζόντια μεταφορά γονιδίου μπορεί να προκαλέσει μεγάλα εξελικτικά άλματα σε σύντομο χρονικό διάστημα. Ένα παράδειγμα αυτού είναι το πώς τα βακτήρια μπορούν γρήγορα να αναπτύξουν αντοχή σε ορισμένα αντιβιοτικά. Αυτό μπορεί να συμβεί με όλα τα είδη γενετικών πληροφοριών και είναι ιδιαίτερα κοινό με τις πρωτεΐνες ροδοψίνης.
«Στη διαδικασία της εξεύρεσης ενός τρόπου για να μετατραπούν οι ροδοψίνες σε πολυκύτταρη μαγιά», είπε ο Burnetti, «βρήκαμε ότι μπορούσαμε να μάθουμε για την οριζόντια μεταφορά ροδοψινών που έχει συμβεί σε όλη την εξέλιξη στο παρελθόν μεταφέροντάς την σε κανονική, μονοκύτταρη μαγιά εκεί που δεν έχει ξαναγίνει».
Κάτω από τα φώτα της δημοσιότητας
Για να δούμε αν θα μπορούσαν να δώσουν σε έναν μονοκύτταρο οργανισμό μια ηλιακή ροδοψίνη, η ομάδα
πρόσθεσε ένα γονίδιο ροδοψίνης που συντέθηκε από έναν παρασιτικό μύκητα
στην κοινή μαγιά αρτοποιίας. Αυτό το μεμονωμένο γονίδιο κωδικοποιείται για μια μορφή ροδοψίνης που θα εισαχθεί στα κύτταρα
κυτταρικό κενό
. Αυτό είναι ένα μέρος του κυττάρου που μπορεί να μετατρέψει τις χημικές διαβαθμίσεις που παράγονται από πρωτεΐνες όπως η ροδοψίνη σε απαραίτητη ενέργεια.
Με αυτήν την κενοτόπια ροδοψίνη, η μαγιά μεγάλωσε
περίπου 2 τοις εκατό πιο γρήγορα
όταν εκτέθηκε στο φως. Σύμφωνα με την ομάδα, αυτό είναι ένα σημαντικό εξελικτικό όφελος και η ευκολία που μπορούν να εξαπλωθούν οι ροδοψίνες σε πολλαπλές γενεές μπορεί να είναι το κλειδί.
«Εδώ έχουμε ένα μόνο γονίδιο, και απλώς το τραβάμε μέσα από τα πλαίσια σε μια γενεαλογία που ποτέ δεν ήταν φωτοτροφική στο παρελθόν, και απλώς λειτουργεί», είπε ο Burnetti. «Αυτό λέει ότι είναι πραγματικά τόσο εύκολο για ένα τέτοιο σύστημα, τουλάχιστον μερικές φορές, να κάνει τη δουλειά του σε έναν νέο οργανισμό».
Οι ζύμες που λειτουργούν καλύτερα στο φως θα μπορούσαν επίσης να αυξήσουν τη διάρκεια ζωής τους. Η λειτουργία των κενοτοπίων μπορεί επίσης να συμβάλει στην κυτταρική γήρανση, επομένως αυτή η ομάδα έχει αρχίσει να συνεργάζεται με άλλες ομάδες για να μελετήσει πώς οι ροδοψίνες μπορούν να μειώσουν τις επιπτώσεις της γήρανσης στη μαγιά. Παρόμοια μαγιά με ηλιακή ενέργεια μελετάται επίσης για την προώθηση των βιοκαυσίμων. Η ομάδα ελπίζει επίσης να μελετήσει πώς η φωτοτροφία αλλάζει το εξελικτικό ταξίδι της ζύμης σε έναν πολυκύτταρο οργανισμό.
VIA:
popsci.com